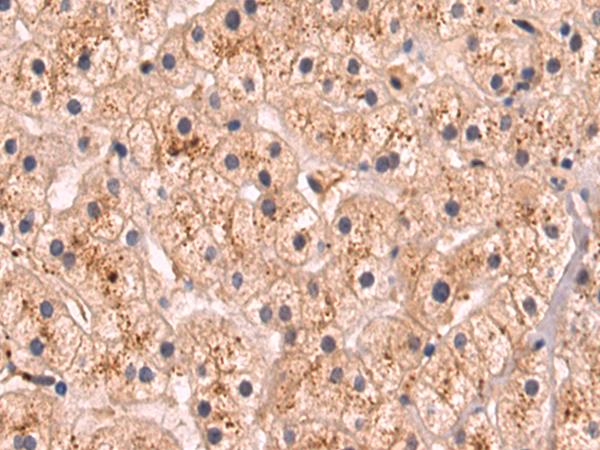

FAM3A蛋白抗体;FAM3A antibody 艾普蒂生物
FAM3A antibody
¥1280
50ul
起订
¥2180
100ul
起订
湖北 更新日期:2025-06-04
产品详情:
- 中文名称:
- FAM3A蛋白抗体;FAM3A antibody
- 英文名称:
- FAM3A antibody
- 品牌:
- 艾普蒂生物
- 产地:
- 湖北武汉
- 保存条件:
- -20℃
- 纯度规格:
- 99%
- 产品类别:
- 抗体
- 货号:
- IPD-ANP8523
- 用途:
- 仅用于科研使用
- 规格:
- 50ul/100ul
- 保质期:
- 1年
- 外观性状:
- 液体
公司简介
湖北艾普蒂生物工程有限公司(简称:艾普蒂)由在国内科研试剂领域有着十几年从业经验的专业技术团队和企业管理团队组建而成,专门从事以抗体、蛋白、细胞、化学品为核心的试剂产品研发与销售。
我们长期聚焦于生命科学、生物医药、医疗诊断、分析检测等领域,专注于为生命科学和生物技术领域的客户提供优质的产品和技术服务。提供生命科学 试剂、供应链服务等,为更多的生命科学科研工作者提供 专业、全面、安全、快捷的产品和服务。产品覆盖 基因、蛋白、细胞、组织、动物等水平的各种研究。
致力于成长为我国重要的生命科学试剂和成果转化一体化的领导者、致力于成为中国大型的科研试剂产品供应商之一。
| 成立日期 | (6年) |
| 注册资本 | 600万(元) |
| 员工人数 | 1-10人 |
| 年营业额 | ¥ 300万-500万 |
| 经营模式 | 工厂,服务 |
| 主营行业 | 中间体,化学试剂,医药原料 |
FAM3A蛋白抗体;FAM3A antibody相关厂家报价
-
- 人FAM3A蛋白(FAM3A)ELISA试剂盒 YB70433Hu
- 上海钰博生物科技有限公司 VIP
- 2026-03-26
- ¥1710
-
- 人FAM3A(蛋白FAM3A)ELISA试剂盒
- 上海信裕生物科技有限公司 VIP
- 2026-03-18
- ¥1785
-
- 小鼠FAM3A蛋白(FAM3A)ELISA试剂盒
- 上海联迈生物工程有限公司 VIP
- 2026-03-24
- ¥1520